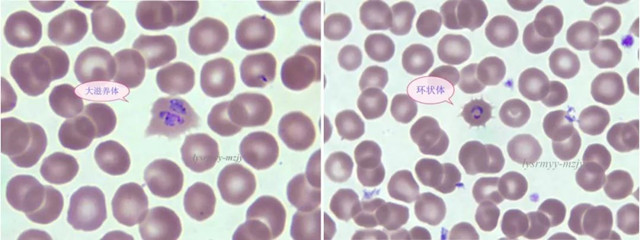

重视仪器报警信息对血常规结果至关重要!
作者:高菊兴 刘中路 郑国娜 韦娜 周艳艳 陈红
单位:临沂市人民医院
近年来出国人员增多,输入性疟疾感染案例屡见不鲜!随着医学发展,检验技术不断优化,血常规作为最基本的检测项目,血液分析仪为我们提供越来越多的诊断信息和思路。下面是我科最近发现的又一例输入性疟疾感染病例,再次体会到严格执行血液复检规则、重视仪器报警信息对检验结果报告至关重要!
1.患者男性,36岁,在加蓬共和国务工8个月,8天前回国后即开始发热,且发热无规律。患者曾在国外发热四次,在当地卫生室做过疟疾免疫检测阳性,并进行了抗疟疾药物治疗。2019年10月11日来医院就诊,检查血常规、CRP及疟原虫。血常规检测结果及报警信息如下:

2.血常规白细胞总数略增高,血小板数值减低,同时报警信息AtypicalLympho、iRBC。异型淋巴?疟原虫?随后查看Q-Flag,AtypicalLympho报警数值210,而“iRBC?”达到300!强烈提示存在疟原虫感染红细胞!

查看WDF通道散点图,在中性粒细胞散点图下方出现一片明显的紫色散点,此即代表疟原虫感染红细胞的信息:

3.仪器报警信息触发了复检规则,XN-9000流水线自动进行涂片染色和形态学图像分析。查看XN-9000图像分析仪图片,发现有疟原虫配子体和滋养体!







5.被感染红细胞周边呈发散状、锯齿状改变是卵形疟原虫感染的重要形态特点!即被感染红细胞周边呈长短不一的毛刺状突起。本例患者见到多量感染红细胞边缘呈典型的发散状、锯齿状改变,多在滋养体期红细胞改变较典型。

6.将患者血标本进行疟原虫免疫胶体金检测,反应结果为T2阳性:


7. 根据疟原虫形态特点和感染红细胞形态学改变,结合免疫检测反应条T2阳性,初步判断该患者感染的是卵形疟原虫。

本例患者上报临沂市疾控中心,疾控中心诊断卵形疟原虫,与我科报告分型一致(不排除存在混合感染可能),目前有待省疾控中心最后确诊。
另外,在本年度我科共检出的十余例疟原虫阳性患者中,多数有血小板减低现象。分析原因,应与患者感染疟原虫后单核-巨噬系统增生导致肝、脾肿大,清扫功能增强,以及骨髓造血功能受抑制有关,在血常规报告时应加以关注。
本案例再次说明,在血液分析中,重视形态学检验、重视复检规则应用以及重视仪器报警信息,对检验结果报告至关重要!根据仪器报警信息提示,进行血液涂片形态学检验,对于异常疾病、异常形态的检出至关重要!
相关知识点链接
1.“iRBC”是“Infect Red Blood Cell”的缩写,即“感染红细胞”。疟疾感染RBC后,经荧光染色红细胞内显示一定的复杂程度。在WDF通道SFL和SSC信号介于NEUT和EO之间,在Ret通道中,SFL信号比RBC略强,介于RBC散点和Ret散点之间,有时也会造成EO和Ret假性偏高。

2. Q-Flag是仪器根据散点图演算出来的某一“报警信息”的阳性等级值。
Q-Flag直接与仪器异常报警信息相关。分为“标本异常”和“异常细胞”。当Q-Flag值超过设定阈值,仪器会提示异常。

“iRBC”的Q-Flag值来自于WDF,其计数细胞粒子数远比人工镜检观察到的细胞数目多。经过荧光染色,应用流式细胞及高灵敏半导体激光技术,极大地提高了异常细胞检出灵敏度。
来源:Sysmex学术二区

